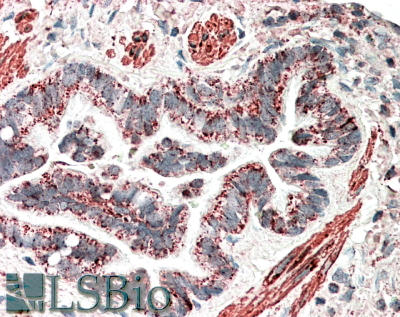

Formulation Supplied at 0.5 mg/ml in Tris saline, 0.02% sodium azide, pH7.3 with 0.5% bovine serum albumin.
| |
Unit Size 100 µg | |
Storage Instructions Aliquot and store at -20°C. Minimize freezing and thawing. | |
Synonym / Alias Names mps one binder kinase activator-like 2| mob2 homolog| HCCA2 protein| HCCA2|MOB2 | |
Accession ID NP_001165694.1; NP_443731.2 | |
Blocking Peptide EBP10797 | |
Immunogen Peptide with sequence DERGKKVKCTAPQ, from the internal region of the protein sequence according to NP_001165694.1; NP_443731.2. | |
Product Comments This antibody is expected to recognize both reported isoforms (NP_001165694.1; NP_443731.2) only. | |
Peptide Sequence DERGKKVKCTAPQ | |
Purification Method Purified from goat serum by ammonium sulphate precipitation followed by antigen affinity chromatography using the immunizing peptide. | |
Shipping Instructions Refrigerated | |
Predicted Species Human, Mouse, Rat, Dog, Cow | |
Reactive Species Human | |
Human Gene ID 81532 | |
Mouse Gene ID 101513 | |
Rat Gene ID 499288 | |
Product Grade ![]() | |
IHC Results In paraffin embedded Human Lung shows staining of smooth muscle cells, vasculature and apical secretory granules in the epithelium of the bronchiole. Recommended concentration: 5-10µg/ml. | |
ELISA Detection Limit Antibody detection limit dilution 1:128000. | |
Western Blot Approx 30kDa band observed in lysates of cell line Jurkat (calculated MW of 30.2kDa according to NP_001165694.1). Recommended concentration: 0.02-0.06µg/ml. An additional band of unknown identity was also consistently observed at 48kDa. This band was successfully blocked by incubation with the immunizing peptide. | |
Application Type Pep-ELISA, WB, IHC |
Goat Anti-MOB2 (aa128-140) Antibody
$431.00
| SKU | Unit Size | Price |
|---|---|---|
Select a unit size:
Selected References [{"pmid": 22566124, "intro": "This antibody has been successfully used in Western blot on Rat:", "title": "Mps one binder 2 gene upregulation in the stellation of astrocytes induced by cAMP-dependent pathway.", "author": "Fang KM, Liu YY, Lin CH, Fan SS, Tsai CH, Tzeng SF.", "journal": "J Cell Biochem. 2012 Sep;113(9):3019-28. doi: 10.1002/jcb.24180."}] |
Documents |